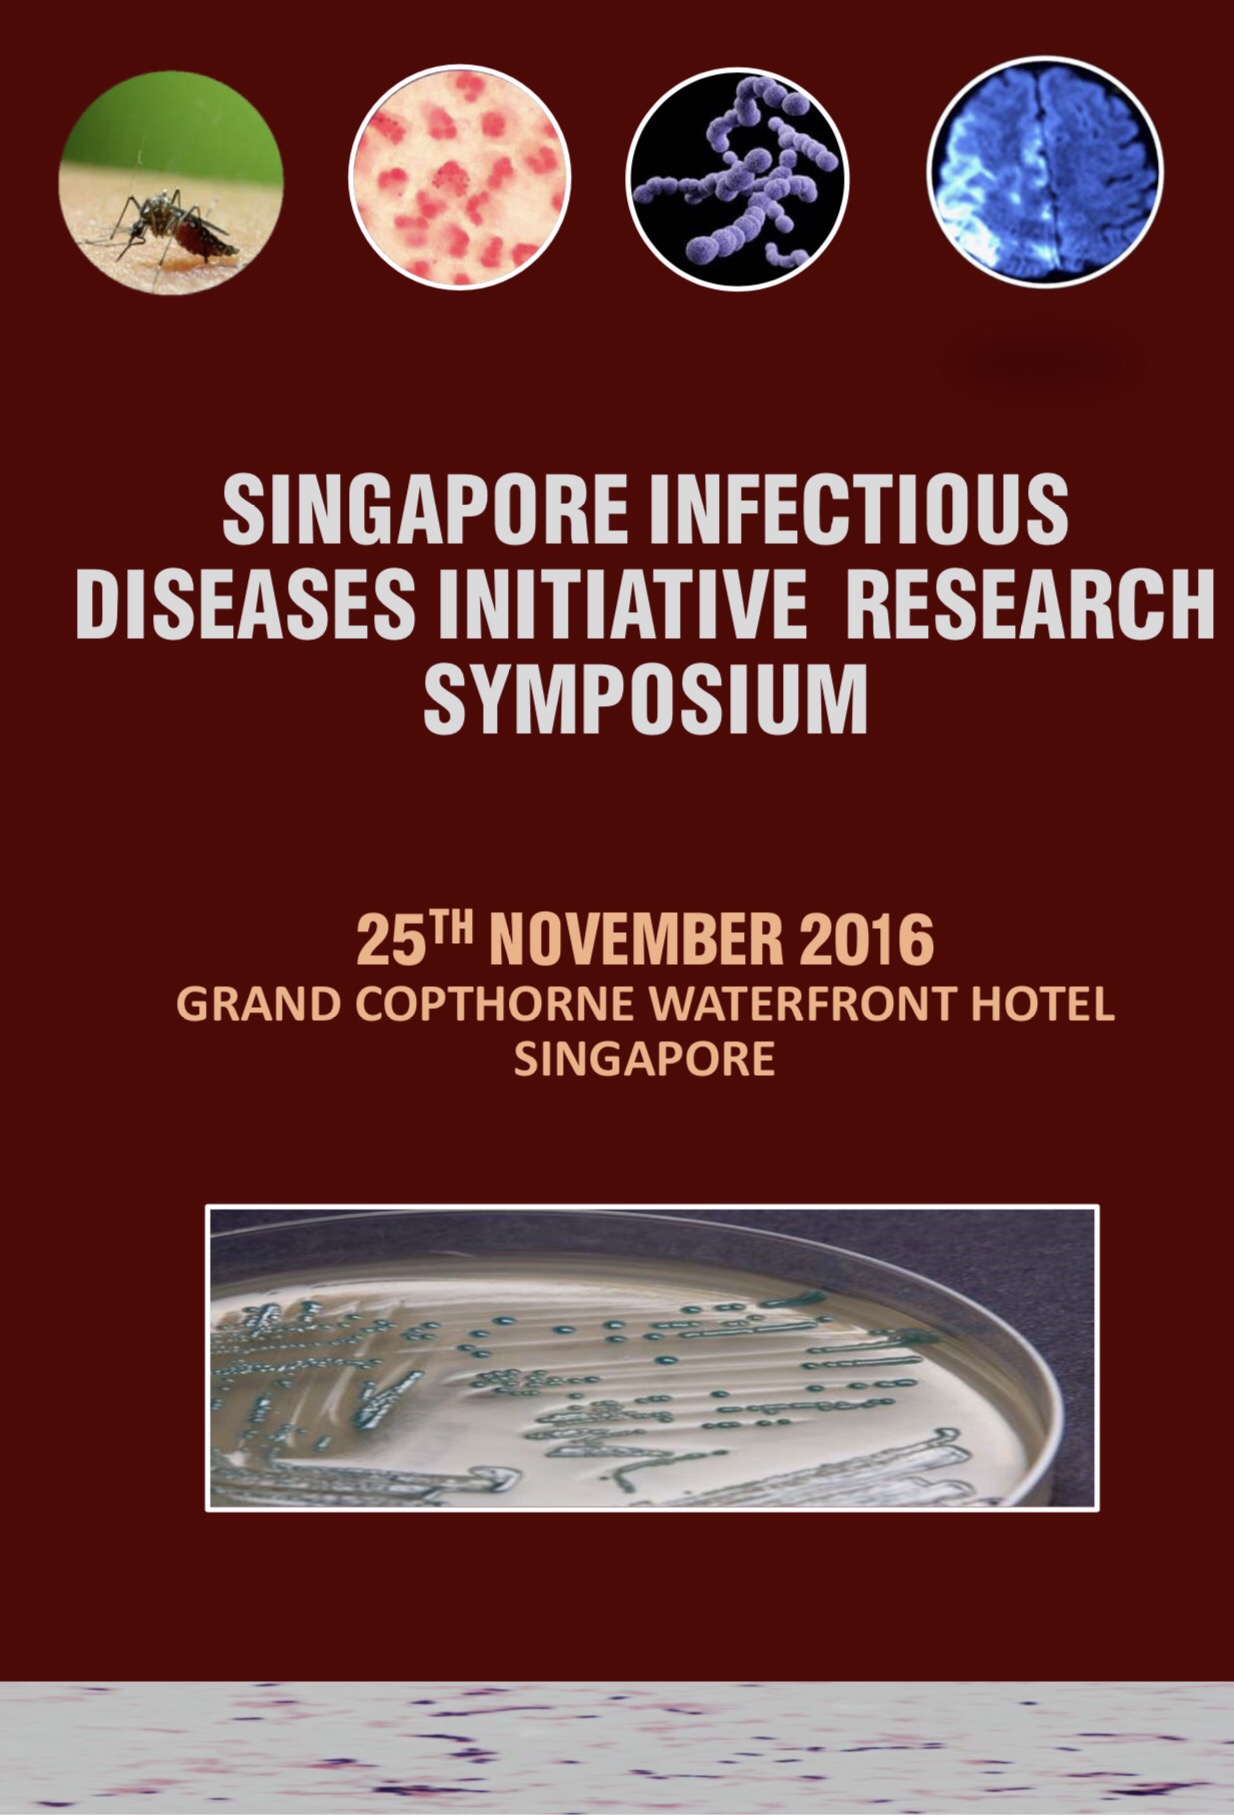

I spent a pleasant afternoon yesterday listening to various presentations on completed and semi-completed projects at the SIDI Research Symposium at Waterfront Copthorne (Declaration: I am the current director of the Singapore Infectious Diseases Initiative, or SIDI for short). The projects were very diverse in nature, ranging from basic science to clinical research as well as research infrastructure building, and on topics that span a considerable breadth of infectious diseases.

Research symposium participants at lunch.

Experimental molecular diagnostics in the Singapore Neurologic Infections Program.

A workmanlike study into maternal-fetal transmission of hepatitis B in infected pregnant women.

The Singapore Acute Respiratory Infection (SARI) Prospective Study – originally funded for influenza A(H7N9) – which was not imported into Singapore. Now a platform for other SARI’s).

Interesting data on ceftriaxone non-susceptibility in Neisseria gonorrhoeae isolates in Singapore.

A large prospective study on carbapenem-resistant Enterobacteriaceae in Singapore hospitals. Worryingly, the investigators have recruited a large number of subjects over a relatively short time period.

An interesting study on a less well-known mosquito in Singapore – Aedes malayensis. Geographically widespread and potentially able to transmit viruses such as the dengue virus.
SIDI was established in 2012 to spur collaborative research into infectious diseases in Singapore, with a generous fund from the Ministry of Health. The key measure of success would be whether investigators would continue to attempt cross-institutional and multidisciplinary research after the original tranche of funding has been fully utilised.